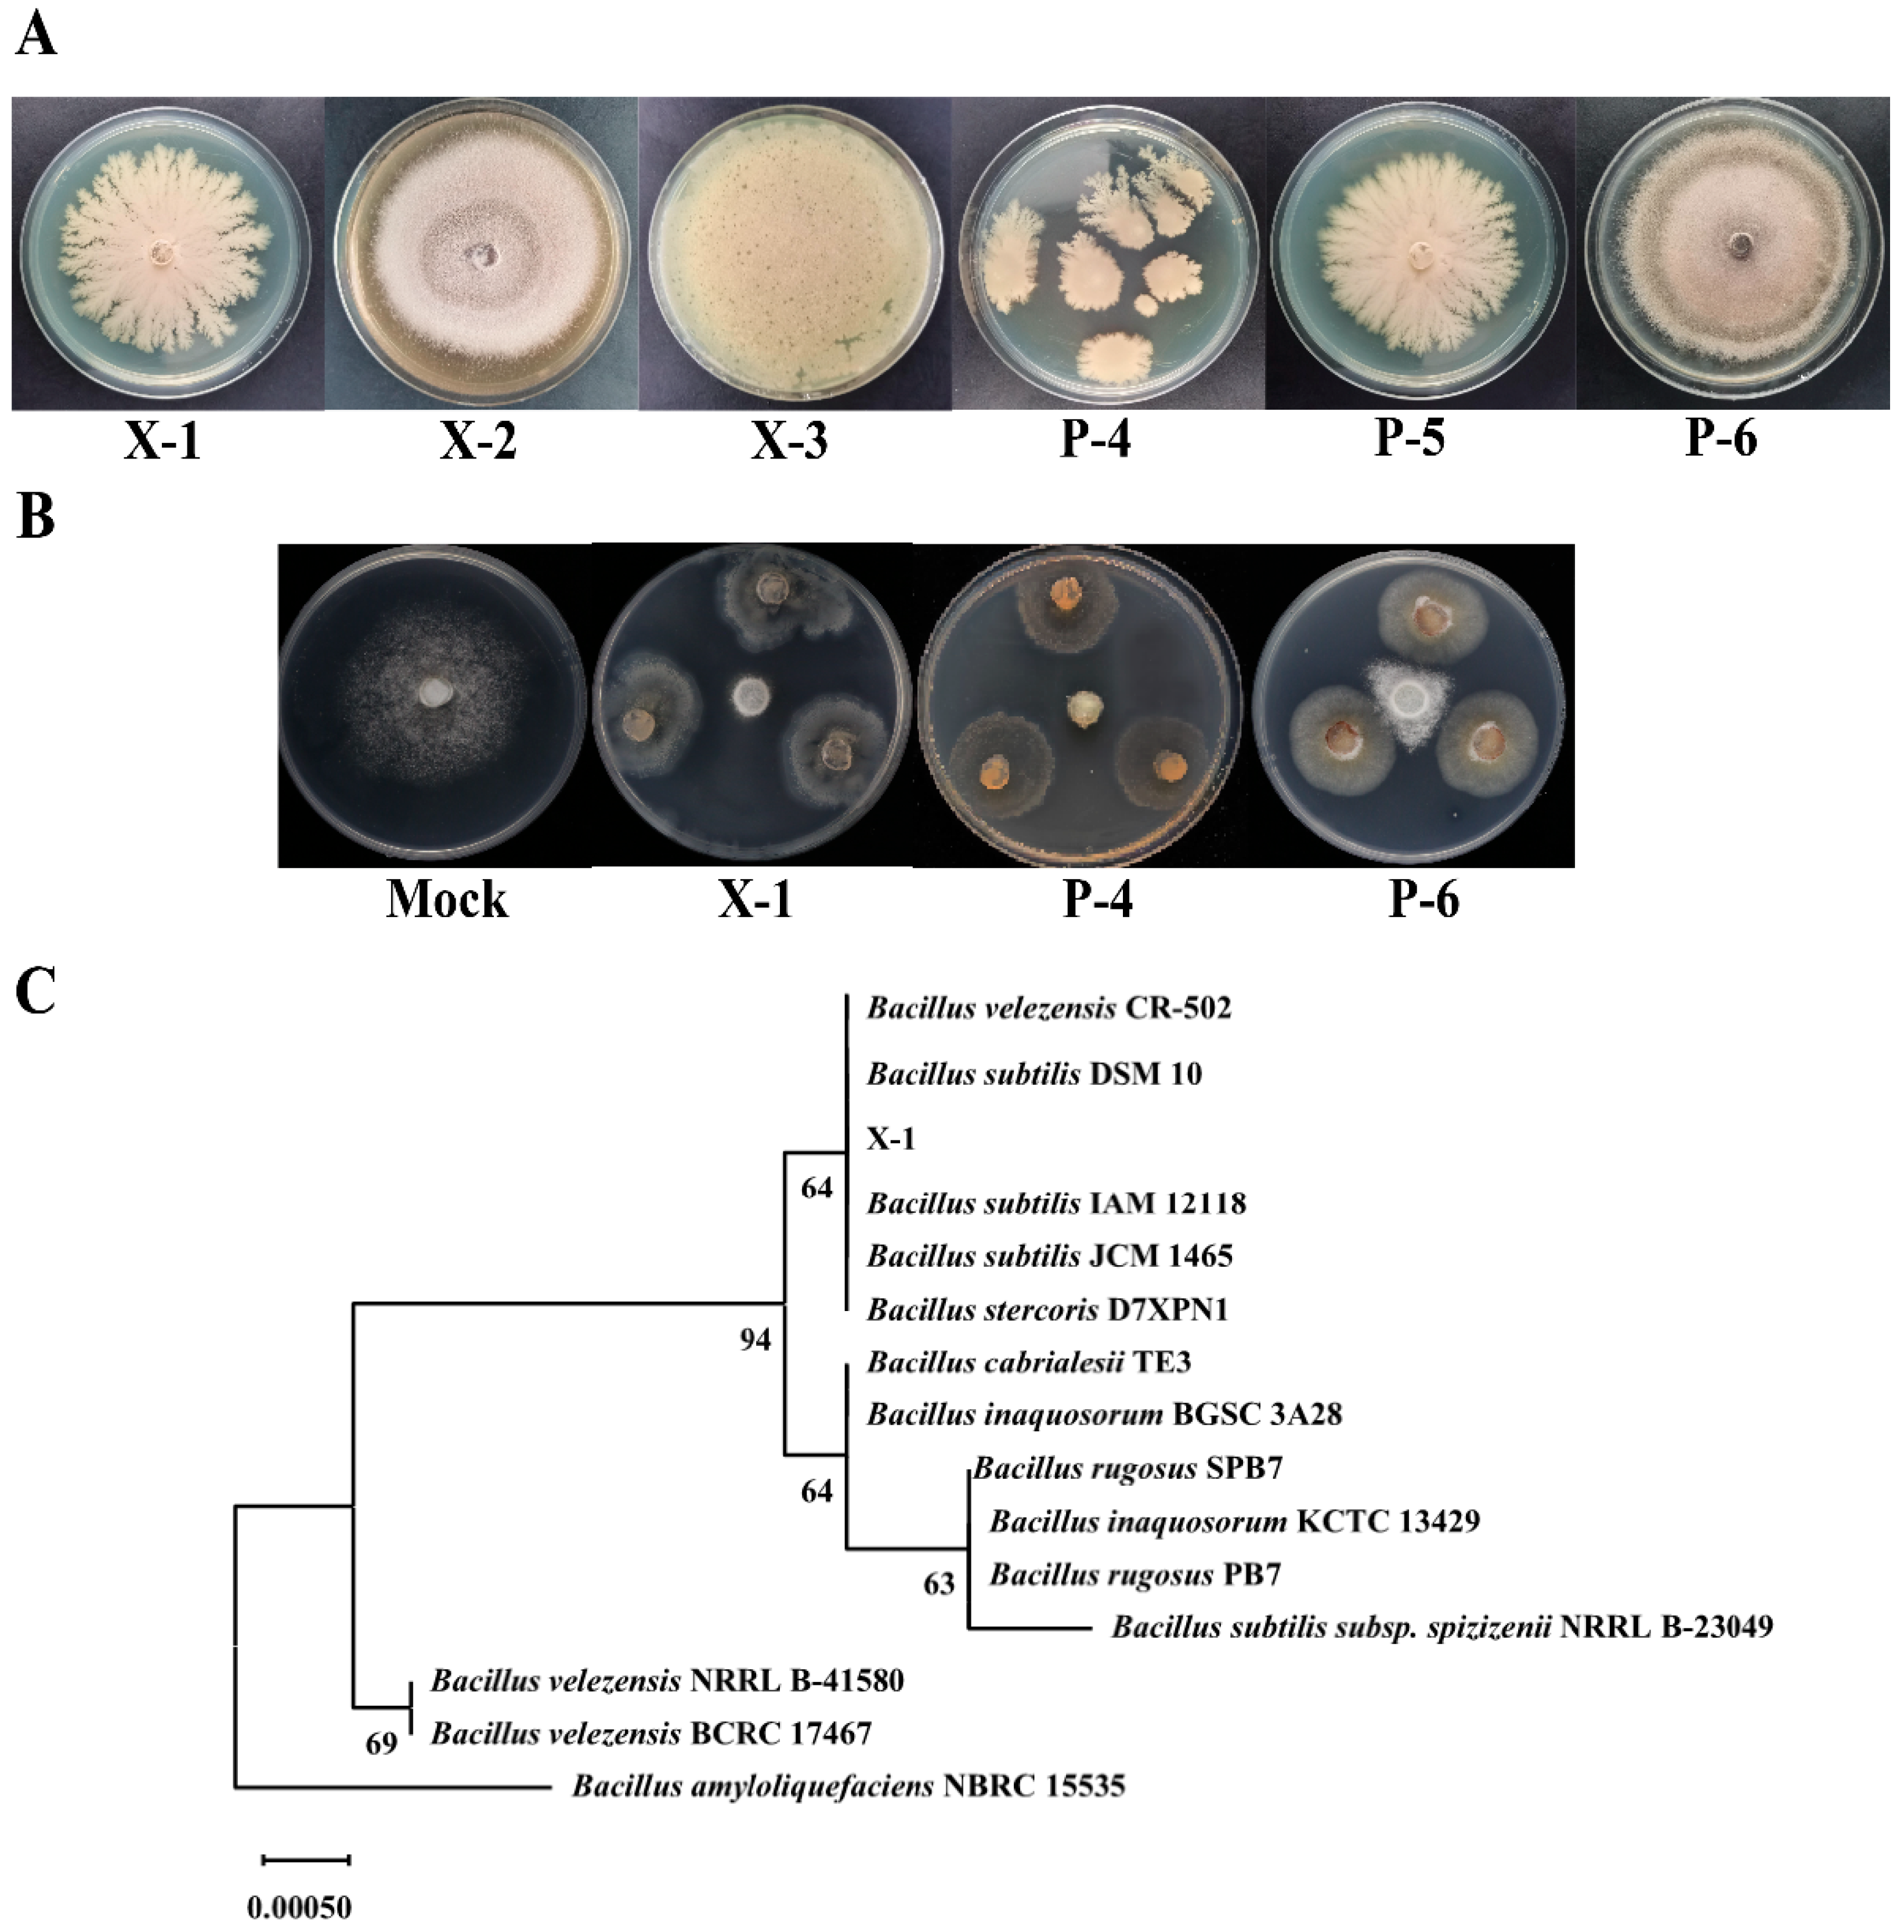
Agronomy 15 00946 g003

An Eco-Friendly Bioformulation Plant Jiaosu Containing Strains with Anti-Oomycete Activity Against Phytophthora infestans
Abstract
1. Introduction
2. Materials and Methods
2.1. Materials
2.2. Anti-Oomycete Effect of PJ on P. infestans
2.3. Bacterial Diversity Sequencing
2.4. Isolation, Purification, and Screening of Anti-Oomycete Strains in PJ
2.5. Tolerance Analysis of Selected Strains
2.6. Identification of Candidate Anti-Oomycete Bacteria
2.7. Effects of Selected Strains on Mycelial Growth and Sporangia Germination of P. infestans
2.8. Localization of Anti-Oomycete Substances in Selected Strains
2.9. Fungicide Tolerance of X-1
2.10. Combined Effect of PJ and Fungticide
2.11. Growth Promotion Experiment with PJ and Anti-Oomycete Effect of PJ Derived from FVW on P. infestans
2.12. Statistical Analysis
3. Results
3.1. Anti-Oomycete Effect of PJ and Localization of Anti-Oomycete Substances
3.2. Bacterial Diversity Analysis of PJ
3.3. Isolation, Purification, Screening, and Identification of Anti-Oomycete Strains from PJ
3.4. Effect of B. subtilis X-1 on Mycelial Growth and Sporangia Germination of P. infestans
3.5. Evaluation of PJ Application Potential
3.6. Anti-Oomycete Effect of PJ Derived from Fruit and Vegetable Waste (FVW) on P. infestans
4. Discussion
5. Conclusions
Supplementary Materials
Author Contributions
Funding
Data Availability Statement
Conflicts of Interest
Abbreviations
| PJ | Plant jiaosu |
| FAO | Food and Agriculture Organization |
| Mock | Control group |
| OJ | Original jiaosu |
| SJ | Sterilized jiaosu |
| FJ | Filtered jiaosu |
| ONJ | PJ derived from onion peels |
| ALJ | PJ derived from asparagus lettuce leaves |
| PEJ | PJ derived from pepper segments |
| ORJ | PJ derived from orange peels |
| GRJ | PJ derived from garlic peels |
| LB | Luria–bertani |
| PDA | Potato dextrose agar |
| NA | Nutrient agar |
References
- Wu, Z.H.; Ma, Q.; Sun, Z.N.; Cui, H.C.; Liu, H.R. Biocontrol mechanism of Myxococcus fulvus B25-I-3 against Phytophthora infestans and its control efficiency on potato late blight. Folia Microbiol. 2021, 66, 555–567. [Google Scholar] [CrossRef] [PubMed]
- Kondhare, K.R.; Natarajan, B.; Banerjee, A.K. Molecular signals that govern tuber development in potato. Int. J. Dev. Biol. 2020, 64, 133–140. [Google Scholar] [CrossRef] [PubMed]
- Food and Agriculture Organization (FAO). Available online: http://www.fao.org/faostat/ (accessed on 4 November 2024).
- Wang, Y.; Pruitt, R.N.; Nürnberger, T.; Wang, Y. Evasion of plant immunity by microbial pathogens. Nat. Rev. Microbiol. 2022, 20, 449–464. [Google Scholar] [CrossRef] [PubMed]
- Sorokan, A.; Benkovskaya, G.; Burkhanova, G.; Blagova, D.; Maksimov, I. Endophytic strain Bacillus subtilis 26DCryChS producing Cry1Ia toxin from Bacillus thuringiensis promotes multifaceted potato defense against Phytophthora infestans (Mont.) de Bary and pest Leptinotarsa decemlineata say. Plants 2020, 9, 1115. [Google Scholar] [CrossRef]
- Fry, W.E.; Birch, P.R.; Judelson, H.S.; Grünwald, N.J.; Danies, G.; Everts, K.L.; Gevens, A.J.; Gugino, B.K.; Johnson, D.A.; Johnson, S.B.; et al. Five reasons to consider Phytophthora infestans a reemerging pathogen. Phytopathology 2015, 105, 966–981. [Google Scholar] [CrossRef]
- Ivanov, A.A.; Ukladov, E.O.; Golubeva, T.S. Phytophthora infestans: An overview of methods and attempts to combat late blight. J. Fungi 2021, 7, 1071. [Google Scholar] [CrossRef]
- Cohen, Y.; Rubin, A.E.; Galperin, M. Effective control of two genotypes of Phytophthora infestans in the field by three oxathiapiprolin fungicidal mixtures. PLoS ONE 2021, 16, e0258280. [Google Scholar] [CrossRef]
- Axel, C.; Zannini, E.; Coffey, A.; Guo, J.; Waters, D.M.; Arendt, E.K. Ecofriendly control of potato late blight causative agent and the potential role of lactic acid bacteria: A review. Appl. Microbiol. Biotechnol. 2012, 96, 37–48. [Google Scholar] [CrossRef]
- Deahl, K.L.; Cooke, L.R.; Black, L.L.; Wang, T.C.; Perez, F.M.; Moravec, B.C.; Quinn, M.; Jones, R.W. Population changes in Phytophthora infestans in Taiwan associated with the appearance of resistance to metalaxyl. Pest Manag. Sci. 2002, 58, 951–958. [Google Scholar] [CrossRef]
- Zhang, X.; Ma, Z.Q.; Feng, J.T.; Wu, H.; Han, L.R. Review on research and development of botanical pesticides. Chin. J. Biol. Control 2015, 31, 685–698. [Google Scholar] [CrossRef]
- Mao, J.W.; Wu, Y.F.; Fang, S. Research progress of microbial enzymes. Bull. Ferment. Sci. Technol. 2010, 39, 42–44. [Google Scholar] [CrossRef]
- Dai, J.; Sha, R.Y.; Wang, Z.Z.; Cui, Y.L.; Fang, S.; Mao, J.W. Edible plant Jiaosu: Manufacturing, bioactive compounds, potential health benefits, and safety aspects. J. Sci. Food Agric. 2020, 100, 5313–5323. [Google Scholar] [CrossRef] [PubMed]
- Zhang, Y.; Zhao, Y.B.; Cai, Y.F.; Liu, X.P.; Hu, Y.G.; Wang, X.F. Ecological effects of plant Jiaosu for agriculture: A review. J. China Agric. Univ. 2020, 25, 25–35. [Google Scholar] [CrossRef]
- Yin, X.J.; Wu, J.; Su, S.P.; Zheng, F.L. Advances in the function and application of fruit and vegetable microbial enzyme. Mod. Chem. Res. 2022, 22, 71–73. [Google Scholar]
- Wang, X.F. Control of potato diseases by plant nutrition immunity. Mod. Agric. 2018, 40, 2–4. [Google Scholar]
- Liang, H.X.; Lian, Y.W.; Sun, W.B.; Zhang, Y.M.; Sun, Z.Y. Effect and mechanism of plant enzymes on potato. Sci-Tech Innov. Brands 2016, 10, 75–77. [Google Scholar]
- Hui, W.; Ma, X.M.; Zhang, Y. Bioactivity and inhibiton effects of greengage ferment. Sci. Technol. Food Ind. 2018, 39, 39–43. [Google Scholar] [CrossRef]
- Jiang, Z. Study on Mechanism of Fermentation, Metabolic Process and Bioactivities of Microbial Natural-Ferments During Fermentation. Master’s Thesis, Zhejiang Sci-Tech University, Hangzhou, China, 2013. [Google Scholar]
- Liu, Y.N.; Cui, N.N.; Zhang, J.; Yu, F.M.; Zhang, L.B.; Yao, Y.C. Effect of aromatic plant-derived nutrient solution on inhibition of harmful bacteria and nutrition for pear plants. Sci. Agric. Sin. 2011, 44, 3981–3990. [Google Scholar]
- Dong, Y.J.; Chen, J.; Yang, X.P.; Han, Y.D.; Wu, Q. Evaluation of antibacterial test of fermented Chinese herbal preparations (Bencaojiaosu) in vitro. Mod. J. Anim. Husb. Vet. Med. 2020, 11, 6–8. [Google Scholar]
- Liu, F.; Wang, F.; Wang, C.; Yin, S.G.; Li, L.H.; Wang, Z.W. Effects of polo microbial enzymes fertilizer application on potato. J. Northeast. Agric. Sci. 2011, 36, 31–32. [Google Scholar] [CrossRef]
- Huo, C.; Cao, J.F.; Yin, R.J.; Yang, M.W.; Zhao, Z.J. First report of Phytophthora infestans causing late blight on pepino (solanum muricatum) in China. Plant Dis. 2023, 107, 3321. [Google Scholar] [CrossRef] [PubMed]
- Wiegand, I.; Hilpert, K.; Hancock, R.E.W. Agar and broth dilution methods to determine the minimal inhibitory concentration (MIC) of antimicrobial substances. Nat. Protoc. 2008, 3, 163–175. [Google Scholar] [CrossRef]
- Buchanan, R.E. Berger Bacterial Identification Manual; Science Press: Beijing, China, 1984. [Google Scholar]
- Dong, X.C.M. Common Bacterial System Identification Manua; Science Press: Beijing, China, 2001. [Google Scholar]
- Jin, Z.J. About the evaluation of drug combination. Acta Pharmacol. Sin. 2004, 25, 146–147. [Google Scholar] [PubMed]
- Yang, X.Q.; Zhao, L.N. Discussion on harmless treatment and reuse of vegetable waste. Agric. Technol. 2019, 39, 23–24. [Google Scholar] [CrossRef]
- Wang, Y.; Pan, S.; Yin, J.; Feng, H.; Wang, M.; Chen, T. Resource potential and global warming potential of fruit and vegetable waste in China based on different treatment strategies. Waste Manag. 2022, 140, 225–232. [Google Scholar] [CrossRef]
- Simsek, S.; El, S.N.; Kancabas Kilinc, A.; Karakaya, S. Vegetable and fermented vegetable juices containing germinated seeds and sprouts of lentil and cowpea. Food Chem. 2014, 156, 289–295. [Google Scholar] [CrossRef]
- Zulkawi, N.; Ng, K.H.; Zamberi, R.; Yeap, S.K.; Satharasinghe, D.; Jaganath, I.B.; Jamaluddin, A.B.; Tan, S.W.; Ho, W.Y.; Alitheen, N.B.; et al. In vitro characterization and in vivo toxicity, antioxidant and immunomodulatory effect of fermented foods; Xeniji™. BMC Complement Altern. Med. 2017, 17, 344. [Google Scholar] [CrossRef]
- Kuwaki, S.; Nakajima, N.; Tanaka, H.; Ishihara, K. Plant-based paste fermented by lactic acid bacteria and yeast: Functional analysis and possibility of application to functional foods. Biochem. Insights 2012, 5, 21–29. [Google Scholar] [CrossRef]
- Zhang, Y.; Gao, Y.H.; Zheng, Z.H.; Meng, X.Y.; Cai, Y.F.; Liu, J.B.; Hu, Y.G.; Yan, S.D.; Wang, X.F. A microbial ecosystem: Agricultural Jiaosu achieves effective and lasting antifungal activity against Botrytis cinerea. AMB Express 2020, 10, 216. [Google Scholar] [CrossRef]
- Gao, Y.H.; Zhang, Y.; Cheng, X.Q.; Zheng, Z.H.; Wu, X.H.; Dong, X.H.; Hu, Y.G.; Wang, X.F. Agricultural Jiaosu: An Eco-Friendly and Cost-Effective Control Strategy for Suppressing Fusarium Root Rot Disease in Astragalus membranaceus. Front. Microbiol. 2022, 13, 823704. [Google Scholar] [CrossRef]
- Fang, S.; Mao, J.W.; Shan, Z.C.; Mao, Y.C.; Li, H.H. Research progress and development suggestions on plant-derived enzyme nutrient solution. Agric. Eng. 2017, 7, 181–186. [Google Scholar]
- Yu, K.; Liu, Y.; Tichelaar, R.; Savant, N.; Lagendijk, E.; van Kuijk, S.J.L.; Stringlis, I.A.; van Dijken, A.J.H.; Pieterse, C.M.J.; Bakker, P.; et al. Rhizosphere-associated pseudomonas suppress local root immune responses by gluconic acid-mediated lowering of environmental pH. Curr. Biol. 2019, 29, 3913–3920.e4. [Google Scholar] [CrossRef]
- Gao, Y.; Zheng, Z.; Cheng, X.; Zhang, Y.; Liu, X.; Hu, Y.; Cai, Y.; Wang, X. An innovative way to treat cash crop wastes: The fermentation characteristics and functional microbial community using different substrates to produce Agricultural Jiaosu. Environ. Res. 2023, 227, 115727. [Google Scholar] [CrossRef] [PubMed]
- Van Wees, S.C.M.; Van der Ent, S.; Pieterse, C.M.J. Plant immune responses triggered by beneficial microbes. Curr. Opin. Plant Biol. 2008, 11, 443–448. [Google Scholar] [CrossRef]
- Singh, S.B.; Young, K.; Silver, L.L. What is an “ideal” antibiotic? Discovery challenges and path forward. Biochem. Pharmacol. 2017, 133, 63–73. [Google Scholar] [CrossRef]
- Akter, S.; Huq, M.A. Biologically rapid synthesis of silver nanoparticles by Sphingobium sp. MAH-11(T) and their antibacterial activity and mechanisms investigation against drug-resistant pathogenic microbes. Artif. Cells Nanomed. Biotechnol. 2020, 48, 672–682. [Google Scholar] [CrossRef]
- Yang, Y.Y.; Yang, L.; Yang, F.Y.; Bai, W.J.; Zhang, X.Q.; Li, H.T.; Duan, G.G.; Xu, Y.T.; Li, Y.W. A bioinspired antibacterial and photothermal membrane for stable and durable clean water remediation. Mater. Horiz. 2023, 10, 268–276. [Google Scholar] [CrossRef]
- Hu, N.; Lei, M.; Zhao, X.; Zhang, Z.; Gu, Y.; Zhang, Y.; Wang, S. Analysis of the Microbial Diversity and Characteristics of Fermented Blueberry Beverages from Different Regions. Foods 2020, 9, 1656. [Google Scholar] [CrossRef] [PubMed]
- Naseer, Q.A.; Xue, X.; Wang, X.; Dang, S.; Din, S.U.; Kalsoom; Jamil, J. Synthesis of silver nanoparticles using Lactobacillus bulgaricus and assessment of their antibacterial potential. Braz. J. Biol. 2021, 82, e232434. [Google Scholar] [CrossRef]
- Jiang, Y.H.; Xin, W.G.; Yang, L.Y.; Ying, J.P.; Zhao, Z.S.; Lin, L.B.; Zhang, X.; Zhang, Q.L. A novel bacteriocin against Staphylococcus aureus from Lactobacillus paracasei isolated from Yunnan traditional fermented yogurt: Purification, antibacterial characterization, and antibiofilm activity. J. Dairy Sci. 2022, 105, 2094–2107. [Google Scholar] [CrossRef]
- Luan, C.; Jiang, N.; Zhou, X.L.; Zhang, C.; Zhao, Y.P.; Li, Z.Q.; Li, C. Antibacterial and anti-biofilm activities of probiotic Lactobacillus curvatus BSF206 and Pediococcus pentosaceus AC1-2 against Streptococcus mutans. Microb. Pathog. 2022, 164, 105446. [Google Scholar] [CrossRef] [PubMed]
- Gil, N.Y.; Gwon, H.M.; Yeo, S.H.; Kim, S.Y. Metabolite profile and immunomodulatory properties of bellflower root vinegar produced using Acetobacter pasteurianus A11-2. Foods 2020, 9, 1063. [Google Scholar] [CrossRef] [PubMed]
- Skowronek, M.; Sajnaga, E.; Kazimierczak, W.; Lis, M.; Wiater, A. Screening and Molecular Identification of Bacteria from the Midgut of Amphimallon solstitiale Larvae Exhibiting Antagonistic Activity against Bacterial Symbionts of Entomopathogenic Nematodes. Int. J. Mol. Sci. 2021, 22, 12005. [Google Scholar] [CrossRef] [PubMed]
- Andreolli, M.; Lampis, S.; Tosi, L.; Marano, V.; Zapparoli, G. Fungicide sensitivity of grapevine bacteria with plant growth-promoting traits and antagonistic activity as non-target microorganisms. World J. Microbiol. Biotechnol. 2023, 39, 121. [Google Scholar] [CrossRef]
- Xie, T.; Shen, S.; Hu, R.; Li, W.; Wang, J. Screening, Identification, and Growth Promotion of Antagonistic Endophytes Associated with Chenopodium quinoa Against Quinoa Pathogens. Phytopathology 2023, 113, 1839–1852. [Google Scholar] [CrossRef]
- Yan, H.H.; Qiu, Y.; Yang, S.; Wang, Y.Q.; Wang, Y.K.; Jiang, L.L.; Wang, H.Y. Antagonistic activity of Bacillus velezensis SDTB038 against Phytophthora infestans in potato. Plant Dis. 2021, 105, 1738–1747. [Google Scholar] [CrossRef]
- Lopes, R.; Tsui, S.; Gonçalves, P.J.R.O.; de Queiroz, M.V. A look into a multifunctional toolbox: Endophytic Bacillus species provide broad and underexploited benefits for plants. World J. Microbiol. Biotechnol. 2018, 34, 94. [Google Scholar] [CrossRef]
- Zhang, J.M.; Huang, X.Q.; Yang, S.D.; Huang, A.R.; Ren, J.; Luo, X.G.; Feng, S.; Li, P.H.; Li, Z.G.; Dong, P. Endophytic Bacillus subtilis H17-16 effectively inhibits Phytophthora infestans, the pathogen of potato late blight, and its potential application. Pest Manag. Sci. 2023, 79, 5073–5086. [Google Scholar] [CrossRef]
- Cho, M.S.; Jin, Y.J.; Kang, B.K.; Park, Y.K.; Kim, C.K.; Park, D.S. Understanding the ontogeny and succession of Bacillus velezensis and B. subtilis subsp. subtilis by focusing on kimchi fermentation. Sci. Rep. 2018, 8, 7045. [Google Scholar] [CrossRef]
- Earl, A.M.; Losick, R.; Kolter, R. Ecology and genomics of Bacillus subtilis. Trends Microbiol. 2008, 16, 269–275. [Google Scholar] [CrossRef]
- Kovács, Á.T. Bacillus subtilis. Trends Microbiol. 2019, 27, 724–725. [Google Scholar] [CrossRef]
- Karpov, D.S.; Domashin, A.I.; Kotlov, M.I.; Osipova, P.G.; Kiseleva, S.V.; Seregina, T.A.; Goncharenko, A.V.; Mironov, A.S.; Karpov, V.L.; Poddubko, S.V. Biotechnological potential of the Bacillus subtilis 20 strain. Mol. Biol. 2020, 54, 137–145. [Google Scholar] [CrossRef]
- Wang, Y.Y.; Zhang, C.Y.; Liang, J.; Wu, L.F.; Gao, W.B.; Jiang, J.Z. Iturin a extracted from Bacillus subtilis WL-2 affects Phytophthora infestans via cell structure disruption, oxidative stress, and energy supply dysfunction. Front. Microbiol. 2020, 11, 536083. [Google Scholar] [CrossRef]
- Alfiky, A.; L’Haridon, F.; Abou-Mansour, E.; Weisskopf, L. Disease inhibiting effect of strain Bacillus subtilis EG21 and Its metabolites against potato pathogens Phytophthora infestans and Rhizoctonia solani. Phytopathology 2022, 112, 2099–2109. [Google Scholar] [CrossRef] [PubMed]
- Zhang, X.J.; Song, W.R.; Chen, H.; Qian, Z.H.; Zeng, J.; Dong, S.M. Status and prospects of chemical prevention and control of potato late blight. China Plant Prot. 2021, 41, 33–39. [Google Scholar]
- Rondeau, S.; Raine, N.E. Fungicides and bees: A review of exposure and risk. Environ. Int. 2022, 165, 107311. [Google Scholar] [CrossRef] [PubMed]
- Kelbessa, B.G.; Ghadamgahi, F.; Kumar, P.L.; Ortiz, R.; Whisson, S.C.; Bhattacharjee, R.; Vetukuri, R.R. Antagonistic and plant growth promotion of rhizobacteria against Phytophthora colocasiae in taro. Front. Plant Sci. 2022, 13, 1035549. [Google Scholar] [CrossRef]
- Kiewnick, S.; Jacobsen, B.J.; Braun-Kiewnick, A.; Eckhoff, J.L.A.; Bergman, J.W. Integrated Control of Rhizoctonia Crown and Root Rot of Sugar Beet with Fungicides and Antagonistic Bacteria. Plant Dis. 2001, 85, 718–722. [Google Scholar] [CrossRef]
- Su, X.; Wu, S.; Liu, L.; Lu, G.; Liu, H.; Jin, X.; Wang, Y.; Guo, H.; Wang, C.; Cheng, H. Potential Antagonistic Bacteria against Verticillium dahliae Isolated from Artificially Infested Nursery. Cells 2021, 10, 3588. [Google Scholar] [CrossRef]
- Saimi, A.; Zhang, Q.; Liu, Q.; Li, G.; Gao, H.; Chen, J. Screening of endophytic antagonistic bacteria in wheat and evaluation of biocontrol potential against wheat stripe rust. Plants 2024, 13, 1366. [Google Scholar] [CrossRef]
- Zhang, Y.; Wang, X.F. Ecological role of agricultural plant jiaosu in organic agricultural production. J. Poyang Lake 2019, 11, 70–74+125–126. [Google Scholar] [CrossRef]

Disclaimer/Publisher’s Note: The statements, opinions and data contained in all publications are solely those of the individual author(s) and contributor(s) and not of MDPI and/or the editor(s). MDPI and/or the editor(s) disclaim responsibility for any injury to people or property resulting from any ideas, methods, instructions or products referred to in the content. |
© 2025 by the authors. Licensee MDPI, Basel, Switzerland. This article is an open access article distributed under the terms and conditions of the Creative Commons Attribution (CC BY) license (https://creativecommons.org/licenses/by/4.0/).
Share and Cite
Xiao, P.; Liu, Y.; He, Y.; Ou, X.; Huang, A.; Lu, C.; Zhu, Z.; Liu, S.; Liu, Y.; Zhang, X.; et al. An Eco-Friendly Bioformulation Plant Jiaosu Containing Strains with Anti-Oomycete Activity Against Phytophthora infestans. Agronomy 2025, 15, 946. https://doi.org/10.3390/agronomy15040946
Xiao P, Liu Y, He Y, Ou X, Huang A, Lu C, Zhu Z, Liu S, Liu Y, Zhang X, et al. An Eco-Friendly Bioformulation Plant Jiaosu Containing Strains with Anti-Oomycete Activity Against Phytophthora infestans. Agronomy. 2025; 15(4):946. https://doi.org/10.3390/agronomy15040946
Chicago/Turabian StyleXiao, Peng, Yuxuan Liu, Yaqi He, Xiaohui Ou, Airong Huang, Chenfei Lu, Zhiming Zhu, Shicheng Liu, Yi Liu, Xinze Zhang, and et al. 2025. "An Eco-Friendly Bioformulation Plant Jiaosu Containing Strains with Anti-Oomycete Activity Against Phytophthora infestans" Agronomy 15, no. 4: 946. https://doi.org/10.3390/agronomy15040946
APA StyleXiao, P., Liu, Y., He, Y., Ou, X., Huang, A., Lu, C., Zhu, Z., Liu, S., Liu, Y., Zhang, X., Yang, L., Shi, L., Zhang, X., Song, D., Zhang, Y., & Dong, P. (2025). An Eco-Friendly Bioformulation Plant Jiaosu Containing Strains with Anti-Oomycete Activity Against Phytophthora infestans. Agronomy, 15(4), 946. https://doi.org/10.3390/agronomy15040946

